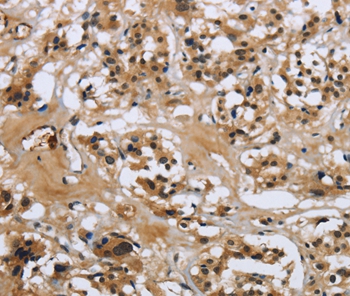

Immunohistochemical staining of human skin shows positivity in epidermal cells.
Anti-LGALS7 Antibody
HPA001549
ApplicationsWestern Blot, ImmunoHistoChemistry
Product group Antibodies
ReactivityHuman
TargetLGALS7
Overview
- SupplierAtlas Antibodies
- Product NameAnti-LGALS7 Antibody
- Delivery Days Customer4
- ApplicationsWestern Blot, ImmunoHistoChemistry
- CertificationResearch Use Only
- ClonalityPolyclonal
- ConjugateUnconjugated
- Gene ID3963
- Target nameLGALS7
- Target descriptiongalectin 7
- Target synonymsGAL7, LGALS7A, galectin-7, lectin, galactoside-binding, soluble, 7
- HostRabbit
- IsotypeIgG
- Protein IDP47929
- Protein NameGalectin-7
- Scientific DescriptionRecombinant Protein Epitope Signature Tag (PrEST) antigen sequence
- ReactivityHuman
- Storage Instruction-20°C,2°C to 8°C
- UNSPSC41116161